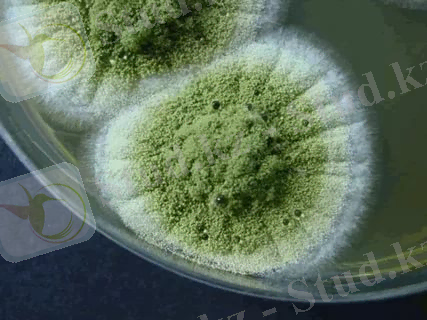
https://im0-tub-kz.yandex.net/i?id=5274ac02c34c16301c06b9e34ad5f422&n=13

Саңырауқұлақтар мен микроорганизмдермен ластанған мал азықтарының жануар организміндегі биологиялық үрдістері және уланудан сақтандыру шаралары


ҚАЗАҚСТАН РЕСПУБЛИКАСЫНЫҢ БІЛІМ ЖӘНЕ ҒЫЛЫМ МИНИСТРЛІГІ СЕМЕЙ қаласының ШӘКӘРІМ атындағы МЕМЛЕКЕТТІК УНИВЕРСИТЕТІ
СӨЖ
Тақырыбы: Саңырауқұлақтар және микрорганизмдермен зақымданған азықтардың құрамына байланысты жануар организміндегі биологиялық үрдісті талдау. Улы өсімдіктермен уланудан сақтандыру іс-шаралары
Тексерген: Жакиянова М. С.
Тобы:ВС-403
Орындаған:Байзақ Н. С.
Семей 2017
ЖОСПАР:
- Кіріспе
- Негізгі бөлім
- Саңырауқұлақтар және микрорганизмдермен зақымданған азықтардың құрамына байланысты жануар организміндегі биологиялық үрдісті талдау.
- Улы өсімдіктермен уланудан сақтандыру іс-шаралары
- Қорытынды
- Пайдаланылған әдебиеттер
Кіріспе
Жануарлар көптеген жағдайларда саңырауқұлақтардан улануы мүмкін. Қорда сақталатын мал азықтарының зең және басқа да саңырауқұлақтардың түрлерімен зақымданатыны жиі кездесетін жағдай. Ондай ортада әртүрлі микроорганизмдердің де өсетіні сөзсіз. Мал азықтары көптеген жағдайларда малдардың улануының көзі болып табылады. мұндай зақымдану өсіп тұрған өсімдіктерде немесе дайындалып, қорда сақталатын азықтардаа жиі кездеседі. Бұл азықтардың зиянды әсерлерін төмендегідей жағдайлармен түсіндіруге болады:
- Саңырауқұлақтар мен микроорганизмдердің даму барысында улы заттар түзіледі;
- Олардың әсерінен бүлінген өсімдіктердің бөліктерінде шіру процесін қолдайтын қоздырғыштар дамып, өздерінің улы заттарын бөледі;
- Организмге түскен кейбір зең саңырауқұлақтары ағзалар мен тіндерде тоғышарлық етеді де, олардың негізгі қызметтерін бұзады.
Саңырауқұлақтардың әсерінен мал организмінде туындайтын ауруларды микотикалық аурулар деп атайды. Олар микоздар және микотоксикоздар болып бөлінеді.
Микозда мал организміне азықпен түскен саңырауқұлақтар ағзалар мен тіндерде өсіп, көбейеді де, организмге жергілікті және жалпы әсер етеді. Ал миктоксикозда олар ағзалар мен тіндерде тоғышарлық етпейді, олардың бөліп шығаратын улы заттары әсер етеді.
Малдар үшін қауіпті саңырауқұлақтардың қатарына зең, тотық, қаштауыш саңырауқұлақтары, стахиботрис және т. б. жатады.
Зең саңырауқұлақтарымен зақымданған азықтармен улану
Зең саңырауқұлақтарының ішінде қалталы, жасыл және басты саңырауқұлақтар мал азықтарын жиі жарақаттайды. Әсіресе ылғалдылығы жоғары және ауа жеткіліксіз жерлерде сақталатын азықтар, олардың ішінде әсіресе бұршақ тұқымдас өсімдіктердің шөбі мен сабаны, жиі зақымданады. Ондай азықтардың түсі қараяды, жағымсыз иіс пайда болады, қышқылдығы жоғарылайды.
Зең саңырауқұлақтарының кейбір түрлерінің улы заттары алкалоидтар болып келеді. Көбінің улылығының негізі жете зерттелмеген. Бірақ та, саңырауқұлақтардың зат алмасу процесін бұзатынын, соның салдарынан организмде улы заттардың түзілетінін, зең саңырауқұлақтарымен зақымданған азықтарды шіру процесін қолдайтын қоздырғыштардың тез дамитынын естен шығармау керек. Сондай ақ, зең саңырауқұлақтарының улылығы тек олардың спора түзетін кезінде болатынын ескерген жөн.
Көгерген азықтармен улану жылқыларда жиі, ал ірі қара мен қойлардың арасында сирек кездеседі. Тауықтар, қаздар, үйректер де уланады.
Зақымданған азықтың улылығы зең саңырауқұлақтарының түріне, вируленттілігіне, мал организмінің резистенттілігіне, азықтың зақымдану деңгейіне, малдың оған дейінгі азықтануына және т. б. жағдайларға тікелей байланысты болады. Осыған байланысты уланудың белгілері де сан алуан болып келеді. Нақтылы диагноз қою үшін малдың азығын мұқият тексеру керек.

Улану жылқыларда үш түрлі болып келеді: өкпелердің, ішектердің және мидың басымырақ зақымдануларына байланысты. Негізгі клиникалық өзгерістер жіті түрдегі гастроэнтеритпен ауыр түрдегі жүйке жүйесінің қызметінің бұзылуының төңірегінде сипатталады. Уланған мал азық қабылдамайды, ауыз қуысынан сілекей ағады, жұтқыншақтың тұсында ауырсынғандық байқалады, мойын тұсындағы лимфа түйіндері ұлғаяды, бас пен мойын бұлшықеттері тартылады, іші өтеді, нәжіс жағымсыз иісті, дем алысы жиілейді, тамыр соғысы әлсіз, дене қызуы көтеріледі, бүйректер мен қуық қабынады, артқы жағы салданады, мал шатқаяқтап қозғалады, көздің қарашығы ұлғаяды.
Сиырлардың іші кебеді, сүт бермейді. Буаздығының соңғы айларында уланған аналық малдарда іш тастау байқалады. Уланудың жіті және созылмалы түрлерін ажыратады.
Зең саңырауқұлақтарымен уланулардың ішінде жылқылыар мен шошқаларда аспергиллотоксикоз жиі анықталады.
Өлекседегі өзгерістер. Жіті түрде уланған жылқының өкпелері ісінген, ас қорыту жүйесінің ағзаларында геморрагиялық қабыну, нефрит, цистит, бауырдың сары атрофиясы, көкбауырда нүктелі геморрагия.
Шошқаларда геморрагиялық диатездің белгілері анықталады, ас қорыту жүйесінің ағзаларында катаральді қабыну, паренхимотозды ағзаларда дистрофиялық өзгерістер.
Емі. Уланған малдарда емдеу таза ғана клиникалық белгілеріне қарсы жүргізіледі. Бірінші кезекте ондай азықты рационнан алып тастайды. Одан кейін уланған малдың ас қорыту жүйесін тазалап, жуады. Ол үшін зонд, жылы су, зарарсыздандыратын әлсіз концентрациялы ерітінділер, іш өткізетін дәрілер қолданады. Кілегейлі тұнбалар, байланыстырғыш дәрілік заттар кеңінен пайдаланылады. Керек болған жағдайда жүректің жұмысын жақсартатын препараттар қолданылады.
Сақтандыру шаралары. Көгеріп, бұзылған азықтарды малға бермеу керек. Немесе өте сақтықпен қолданған жөн. Мал азығы аздап зақымданған кезде ол азықты араластырып, қағып, сілкіп, күн көзіне кептіргеннің өзі жеткілікті болуы мүмкін. Зақымданған азықты известтің ерітіндісімен өңдегенде зарарсыздандырылып қана қоймайды, сонымен қатар оның жұғымдылығы артады.
Кейбір жағдайд биологиялық бақылау жүргізіп алуға болады. Ол үшін онша құнды емес бірнеше бас малға бірнеше күн азықты береді де, клиникалық бақылау жасайды.
Жалпы мал азығын дайындау кезінде оның технологиясын дұрыс сақтағанда онда зең саңырауқұлақтарымен зақымдану болмайды.
Спорыньямен улану
Мұндай улану қалталы саңырауқұлаққа жатады. Бұл саңырауқұлақ мәдени дәнді дақылдар мен шабындықтарда өсетін дәнді өсімдіктерді зақымдайтын өте қатал тоғышар. Дәнді дақылдардың ішінде қара бидай жиі зақымдалынады. Сондай дақылдардың диірмен қалдықтарымен малдарды азықтандырғанда улану байқалады. Өсімдік жауынды жылдары көп өседі, малдардың онымен улануы жиі кездеседі. Егістіктерде агротехникалық іс шараларды дұрыс жүргізгенде дәнді дақылдардың зақымдануы да аз болады.
Малдарға спорыньяның алты жұп алкалоиды улылық әсер етеді. Олар: эргокристин, эргокриптин, эргокорнин, эрготамин, эргозин және эргометрин. Алкалоидтардың жинақталуы біркелкі болмайды. Оған сыртқы факторлар әсер етеді. Сондықтан оның улылығы әр кезде әр түрлі болып келеді.
Малдардыі ішінде шошқалар, ірі қара малдары және құстар сезімтал болып келеді. Малдар негізінен тспорыньямен ластанған ұнмен, кебекпен, астық қалдықтарымен азықтанғанда уланады. Ал төлдер аналық малдың сүті арқылы да улынуы мүмкін.
Спорыньямен уланғанда пайда болатын ауру эрготизм деп аталады. Оның жіті және созылмалы түрлері бар. Жіті түрінде негізгі клиникалық өзгерістер ас қорыту және жүйке жүйелері жағынан болады. Ауыр жағдайда уланған мал тез арада өліп кетуі мүмкін.
Уланудың созылмалы түрінде шеткері ағзаларда құрғақ гангрена дамиды: құстардың айдаршасы мен сырғасы, ірі қараның құлағы, аяқтарының бақайлары, құйрығының үші, емшектері өлі еттенеді, артынан түсіп қалады. Терілердің кейбір жерлерінде де болады.
Емі. Малдың рационын тазалайды. Жылқылардың асқазанын сумен, таниннің ертіндісімен жуады. Іш өткізетін, құстыратын препараттарды қолданады. Кілегейлі қайнатпаны, байланыстыратын заттарды береді. Уланудың клиникасына қарсы: дірілдеп қалшылдауға қарсы: хлоргидратпен клизма қояды; депрессияға кофеинді, камфораны терінің астына жібереді. Хлорлы кальций, глюкоза ертінділерін венаға жібереді. Тиісті антибиотиктерді қолдануға болады.
Сақтандыру шаралары. Ұн, кебек құрамында 0, 2% дан жоғары спорынья болғанда қауіпті болып келеді. Егістіктің таза болуын қадағалау керек. Ол үшін егінді егу технологиясын қатаң сақтау керек.


Шөп биті- Травяная тля
Көптеген бұршақты өсімдіктердің тоғышары ретінде кездеседі. Ол ең алдымен өсімдіктің өзіне зиян келтіреді. Өзінің тұмсығы арқылы өсімдіктің кез келген жерін тесіп, оның сөлін сорып алады. Олар өсімдік жапырағының астыңғы жағында, сабағында, гүлінде тұтасып жабысып тұрады. Жапырақтарын істен шығарады, өсімдік өспейді, өледі.
Сондай өсімдікті жеген мал терісінің пигментсіз жерлерінде қабыну процесі дамиды, ол жерде күлдіреуік пайда болады, ол жарылады да орнында жара анықталынады. Ол жара іріңдейді, өліеттенеді, гангренаға айналады. Сондай ақ, көздің зақымданғаны байқалады. Ондай зақымданған мал азықтарын кептіріп, жуып барып азық ретінде қолдануға болады.


Қырыққабат қырықбуыны- Гусеницы капустиниц
Көбінесе қырыққабатты, брюкваны, рапсты зақымдайтын жәндік. Ондай өсімдікті жеген ірі қара малының ауыз қуысының кілегей қабықтары қабынады, қанаралас зәр бөлінеді, малдың артқы жағының әлсіздігі байқалады. Өсімдіктегі ол жәндікті құрту үшін жіберілген үйректердің онымен уланғаны және жартысынан көбінің өлгені туралы деректер бар.
Жәндіктің сыртының түктері кілегей қабықтарды тітіркендіретін болса, олардың бөліп шығаратын улы заттары малды уландырады.
Астық қоймаларында кездесетін қойма ұзынтұмсықтары мен дәнді дақыл кенелері мал азықтарын ластап, зақымдайды. Ондай азықпен азықтанған малдар әртүрлі ауруларға шалдығуы мүмкін.


Улы өсімдіктермен уланудан сақтандыру іс-шаралары
Малдарды уланудан сақтандырудың ең тиімді жолы жайылым мен шабындықтардағы улы өсімдіктерді мүмкіндігінше жою болып табылады.
Ол үшін агротехникалық:(құрғату, әк, гипсті ерітінділерді пайдалану т. б) шараларды жүргізеді. Сондай-ақ, егістік жерлерді мұқият түрде тыңғылықты өңдеуден, тұқымдық материалдарды жақсы тазалаудың, егіс айналымын белгілі бір жүйемен жүргізудің маңызы өте зор. Малдың жайылымын дұрыс күту, керексіз өсімдіктерді уақытында шауып тастау, т. б
Жайылымды дұрыс таңдай білу, шөп құрамын, сапасын, улы өсімдіктердің бар жоғын мұқият танысу.
Улы өсімдіктердің бар жоғын, алдыңғы жайылған малдардың жемемй қалдырып кеткен өсімдіктердің түрлерінен қарап та көңіл аударуға болады. Көптеген улы өсімдіктерді олардың кейбір қасиеттеріне байланысты малдар жемейді. Мұндай әдіс жайылымдарды таңдауға, кейбір белгісіз өсімдіктерді анықтауға көп көмегін тигізеді.
Көптеген улы өсімдіктер жазғытұрым ерте шыға бастайды, олар орманды, батпақты, ылғалды жерлерде көп өседі. Сондықтанда малдарды жазғытұрым негізгі азықтық өсімдіктер жақсы шыққан кезде жайған дұрыс. Қыстай байлауда тұрған мал алғаш рет жайылымға шыққанда кез келген жасыл шөптерге әуес келеді, улы шөптерді ажырата алмай қалады. Міне, сол кезде малдардың арасында уланулар жиі кездеседі. Сондықтан қыстан кейін малдарды алғашқы рет жайылымғы шығармас бұрын оларды азықтандырып алуды ұсынады. Әсіресе малдарды өсімдіктердің түп жағы қалған жайылымдарға жаю өте қауіпті. Кейбір кезде құғақшылықтан және үсік жүргеннен кейін жайылымдарға малды жаю да қауіпті. Ондай жерлерге аш малдарды жаймау керек.
Мал жалайтын тұз - циагенді өсімдіктермен уланулары азаяды. Фагопиризм сезіле бастағанда малдарды көлеңкелеу жерге ұстау керек. Ондай жағдайда кешке немесе бұлтты күні жаю тәжірбиеде бар.
Кейбір улы өсімдіктердің улылығы кепкеннен кейін жойылатынын ескере отырып, ондай жайылымдарды шабындыққа айналдырған дұрыс. Жайылымдағы малдың көңіл-күйін үнемі қадағалап отыру қажет.
Қойларды йодталған ас тұзымен қамтамасыз етудің де маңызы бар. Оны жайылымға шығарар алдында және жайылымнан келгеннен кейін іске асырған жөн. Ірі қойларға бір басқа 20-25 г, ал қозыларға 10г мөлшерінде.
... жалғасы- Іс жүргізу
- Автоматтандыру, Техника
- Алғашқы әскери дайындық
- Астрономия
- Ауыл шаруашылығы
- Банк ісі
- Бизнесті бағалау
- Биология
- Бухгалтерлік іс
- Валеология
- Ветеринария
- География
- Геология, Геофизика, Геодезия
- Дін
- Ет, сүт, шарап өнімдері
- Жалпы тарих
- Жер кадастрі, Жылжымайтын мүлік
- Журналистика
- Информатика
- Кеден ісі
- Маркетинг
- Математика, Геометрия
- Медицина
- Мемлекеттік басқару
- Менеджмент
- Мұнай, Газ
- Мұрағат ісі
- Мәдениеттану
- ОБЖ (Основы безопасности жизнедеятельности)
- Педагогика
- Полиграфия
- Психология
- Салық
- Саясаттану
- Сақтандыру
- Сертификаттау, стандарттау
- Социология, Демография
- Спорт
- Статистика
- Тілтану, Филология
- Тарихи тұлғалар
- Тау-кен ісі
- Транспорт
- Туризм
- Физика
- Философия
- Халықаралық қатынастар
- Химия
- Экология, Қоршаған ортаны қорғау
- Экономика
- Экономикалық география
- Электротехника
- Қазақстан тарихы
- Қаржы
- Құрылыс
- Құқық, Криминалистика
- Әдебиет
- Өнер, музыка
- Өнеркәсіп, Өндіріс
Қазақ тілінде жазылған рефераттар, курстық жұмыстар, дипломдық жұмыстар бойынша біздің қор #1 болып табылады.



Ақпарат
Қосымша
Email: info@stud.kz